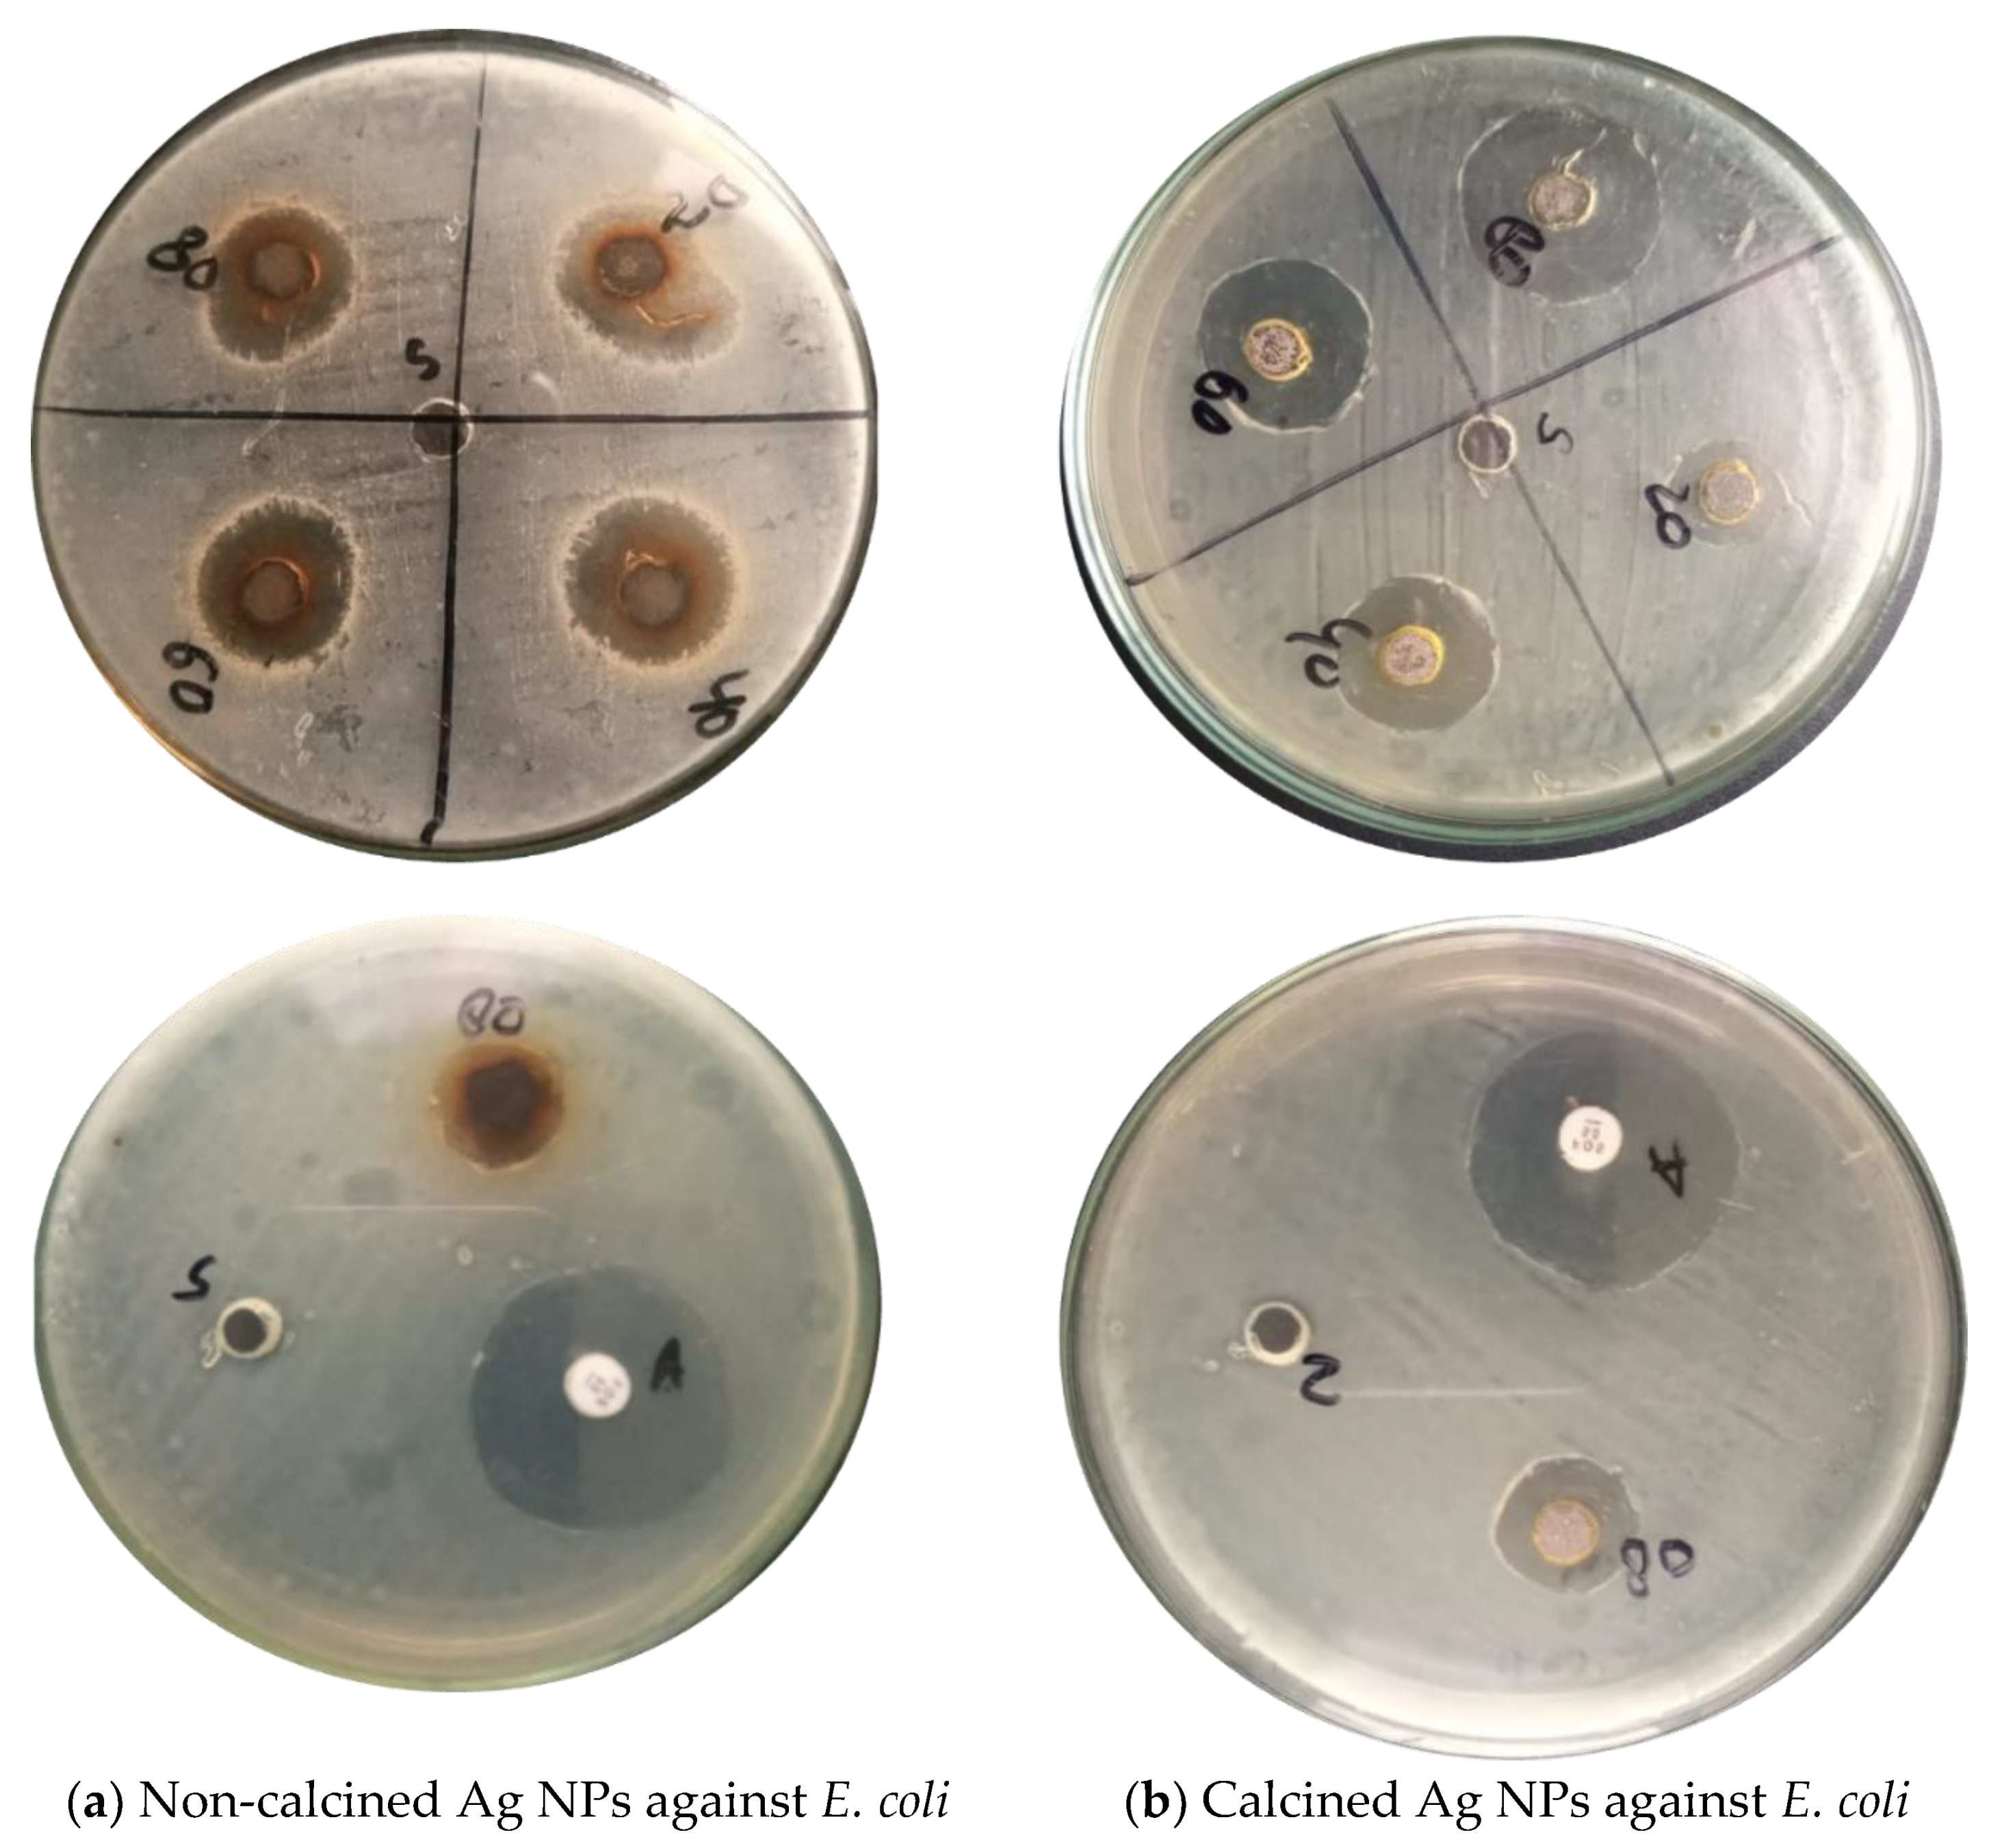
Materials 16 00129 g006 Materials 16 00129 g006
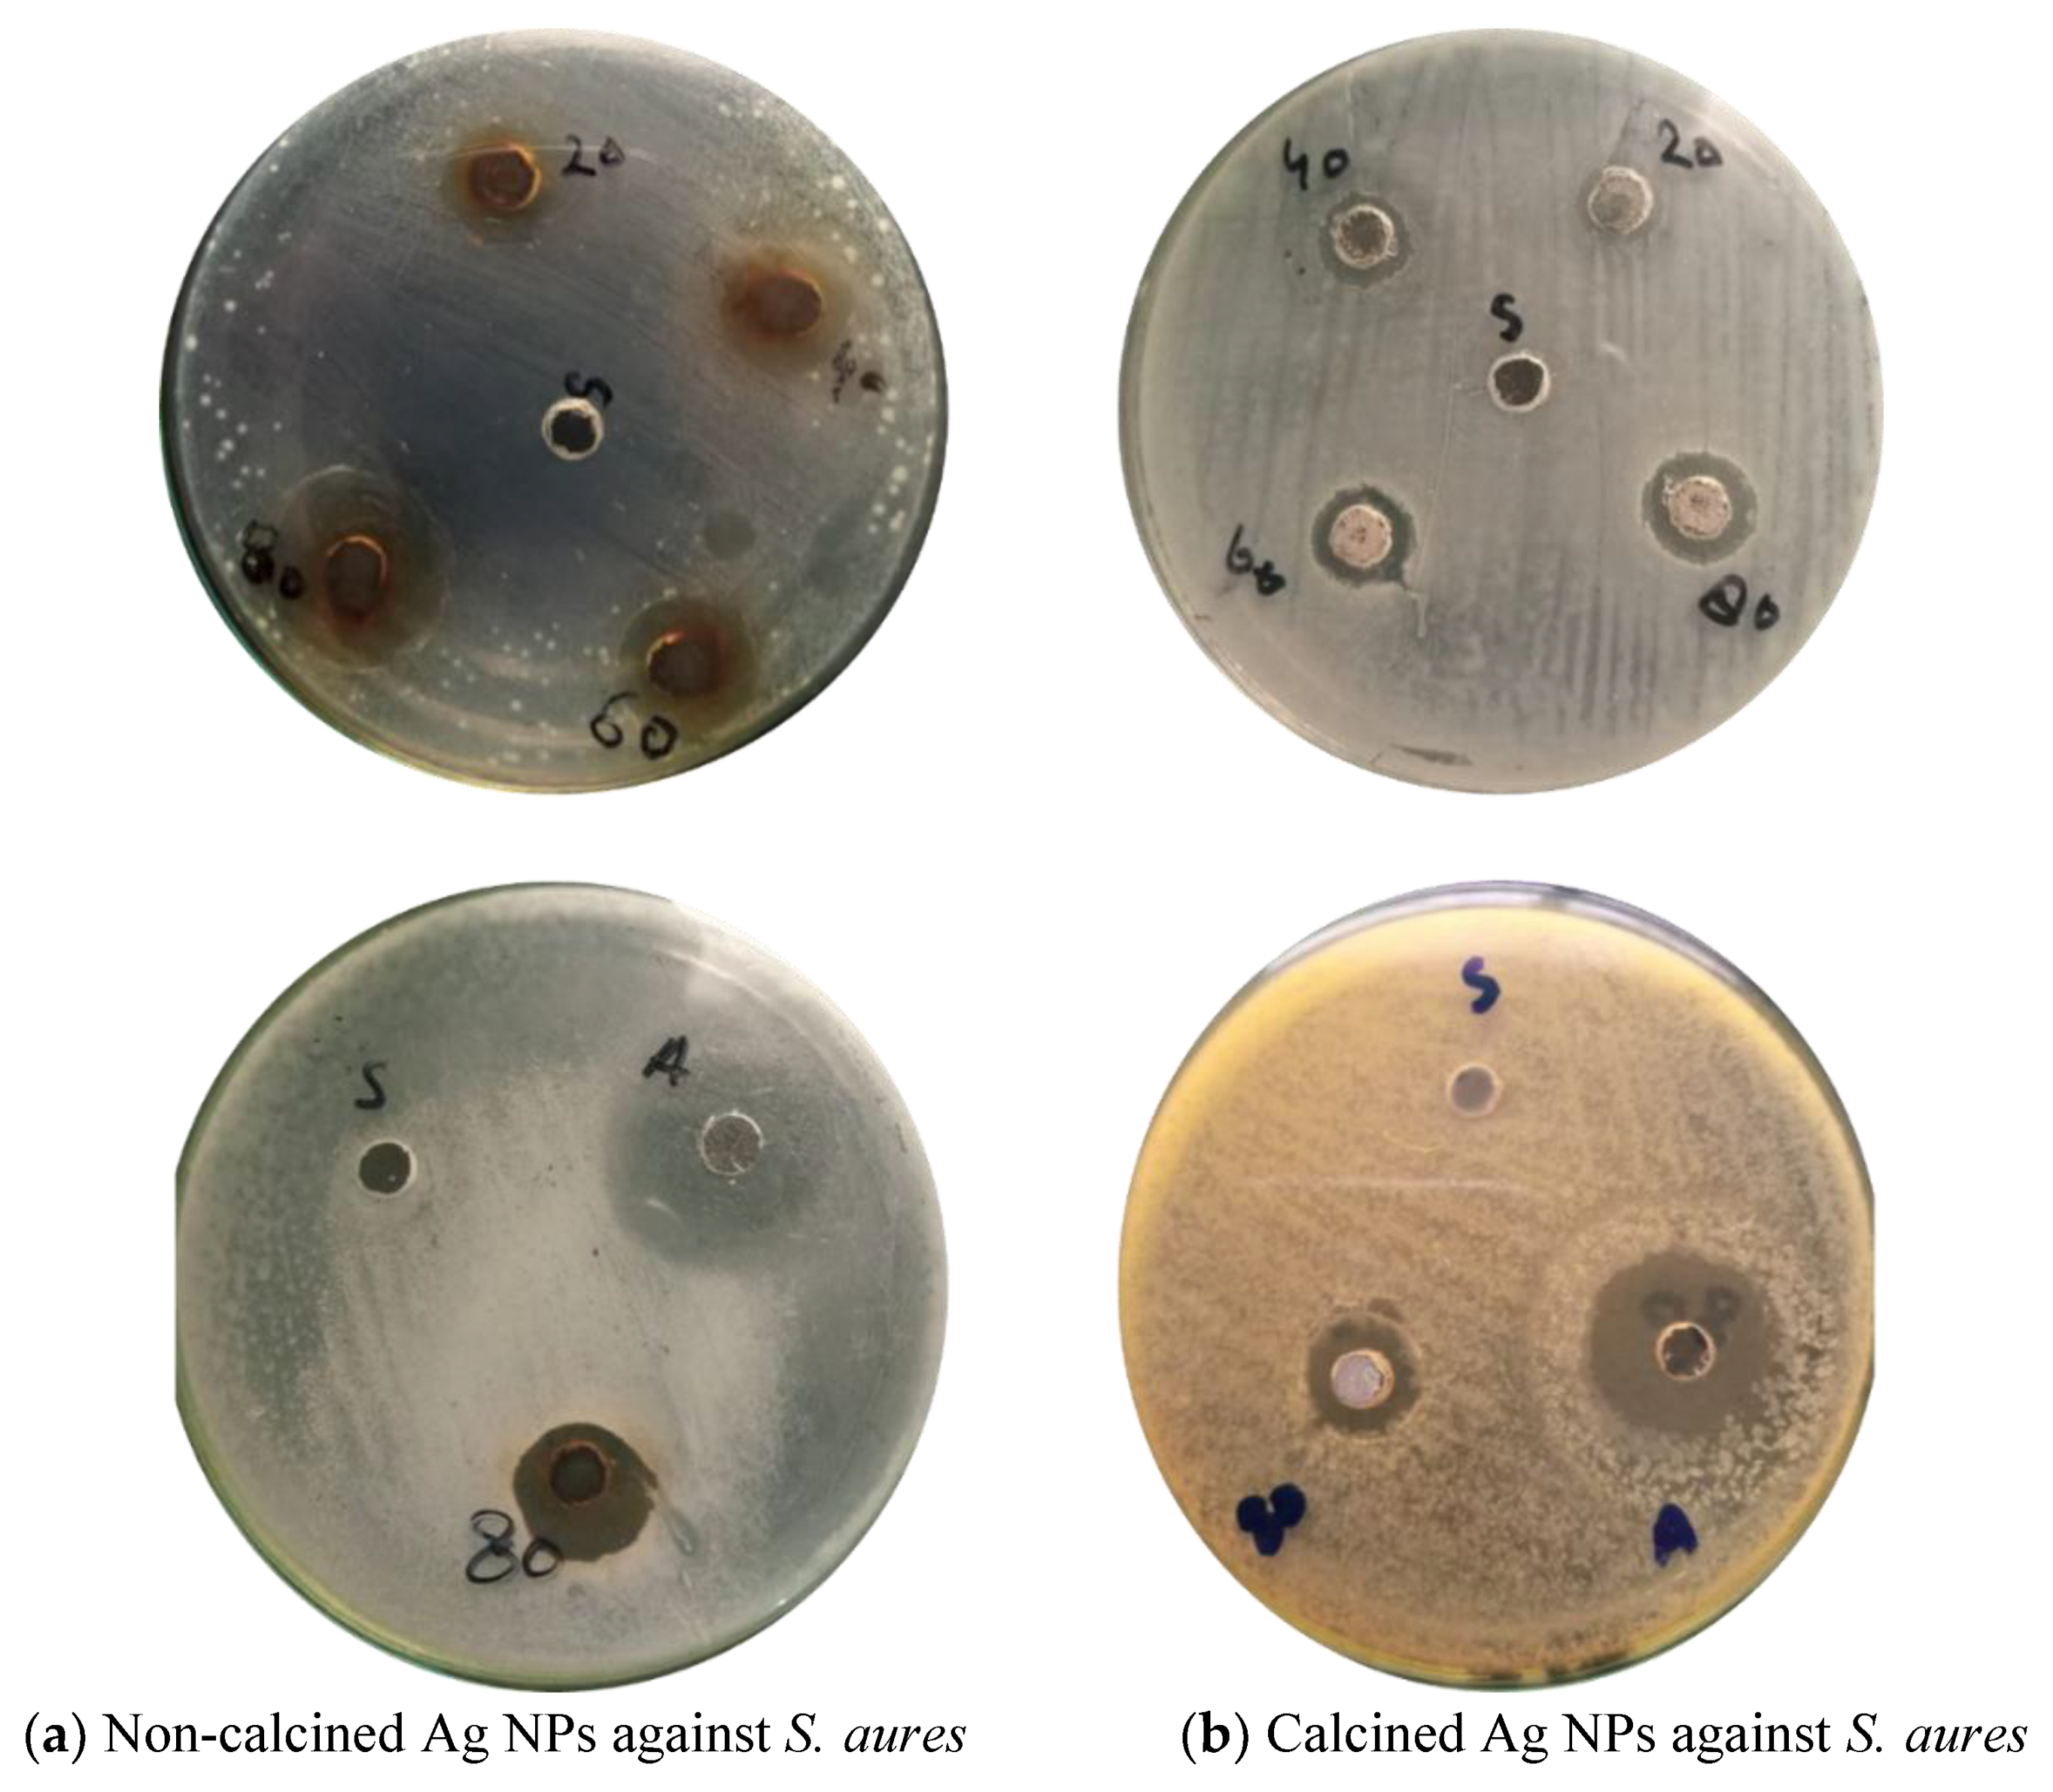
Materials 16 00129 g007 Materials 16 00129 g007

Green Synthesis of Silver Nanoparticles (Ag-NPs) Using Debregeasia Salicifolia for Biological Applications
Abstract
1. Introduction
2. Experimental Section
2.1. Chemicals and Plant Materials
2.2. Preparation of Plant Leaves Extract
2.3. Biogenic Synthesis of Ag NPs
2.4. Characterization
2.4.1. UV–Visible Spectroscopy
2.4.2. Scanning Electron Microscopy (SEM)
2.4.3. Fourier-Transform Infrared Spectroscopy
2.4.4. X-ray Diffraction Analysis (XRD)
2.5. Antibacterial Activity of Ag NPs
2.6. Antioxidant Activity
3. Results and Discussion
3.1. UV-Visible Spectroscopy
3.2. FT-IR Spectroscopy
3.3. X-ray Diffraction (XRD) Analysis
3.4. Scanning Electron Microscopy (SEM)
3.5. Antibacterial Activity of biogenic Ag NPs
3.6. Antioxidant Activity of Biogenic Ag NPs
4. Conclusions
Author Contributions
Funding
Institutional Review Board Statement
Informed Consent Statement
Data Availability Statement
Acknowledgments
Conflicts of Interest
References
- Han, X.; Yang, S.; Schröder, M. Porous metal–organic frameworks as emerging sorbents for clean air. Nat. Rev. Chem. 2019, 3, 108–118. [Google Scholar] [CrossRef]
 - Faustini, M. Patterning MOFs at smaller scales. Nat. Mater. 2021, 20, 8–9. [Google Scholar] [CrossRef] [PubMed]
 - Jiang, H.L.; Feng, D.; Wang, K.; Gu, Z.Y.; Wei, Z.; Chen, Y.P.; Zhou, H.C. An exceptionally stable, porphyrinic Zr metal-organic framework exhibiting pH-dependent fluorescence. J. Am. Chem. Soc. 2013, 135, 13934–13938. [Google Scholar] [CrossRef] [PubMed]
 - Khan, J.; Ilyas, S.; Akram, B.; Ahmad, K.; Hafeez, M.; Siddiq, M.; Ashraf, M.A. Zno/NiO coated multi-walled carbon nanotubes for textile dyes degradation. Arab. J. Chem. 2018, 11, 880–896. [Google Scholar] [CrossRef]
 - Lee, S.; Oh, S.; Oh, M. Atypical Hybrid Metal-Organic Frameworks (MOFs): A Combinative Process for MOF-on-MOF Growth, Etching, and Structure Transformation. Angew. Chem. Int. Ed. Engl. 2020, 59, 1327–1333. [Google Scholar] [CrossRef]
 - Liu, J.; Thallapally, P.K.; McGrail, B.P.; Brown, D.R.; Liu, J. Progress in adsorption-based CO2 capture by metal-organic frameworks. Chem. Soc. Rev. 2012, 41, 2308–2322. [Google Scholar] [CrossRef]
 - Thompson, B.C.; Moulton, S.E.; Ding, J.; Richardson, R.; Cameron, A.; O’Leary, S.; Wallace, G.G.; Clark, G.M. Optimising the incorporation and release of a neurotrophic factor using conducting polypyrrole. J. Control. Release 2006, 116, 285–294. [Google Scholar] [CrossRef]
 - Sahoo, S.C.; Kundu, T.; Banerjee, R. Helical water chain mediated proton conductivity in homochiral metal-organic frameworks with unprecedented zeolitic unh-topology. J. Am. Chem. Soc. 2011, 133, 17950–17958. [Google Scholar] [CrossRef]
 - Kanti Das, T.; Ganguly, S.; Remanan, S.; Das, N.C. Temperature-dependent study of catalytic Ag nanoparticles entrapped resin nanocomposite towards reduction of 4-Nitrophenol. ChemistrySelect 2019, 4, 3665–3671. [Google Scholar] [CrossRef]
 - Das, T.K.; Das, N.C. Advances on catalytic reduction of 4-nitrophenol by nanostructured materials as benchmark reaction. Int. Nano Lett. 2022, 4, 223–242. [Google Scholar] [CrossRef]
 - Rafiqi, F.A.; Majid, K. Synthesis, characterization, luminescence properties and thermal studies of polyaniline and polythiophene composites with rare earth terbium(III) complex. Synth. Met. 2015, 202, 147–156. [Google Scholar] [CrossRef]
 - Mathur, S.; Veith, M.; Shen, H.; Hufner, S.; Jilavi, M.H. Structural and Optical Properties of NdAlO3 Nanocrystals Embedded in an Al2O3 Matrix. Chem. Mater. 2002, 14, 568–582. [Google Scholar] [CrossRef]
 - Rojas, S.; Horcajada, P. Metal-Organic Frameworks for the Removal of Emerging Organic Contaminants in Water. Chem. Rev. 2020, 120, 8378–8415. [Google Scholar] [CrossRef] [PubMed]
 - Usman, M.; Lu, K.-L. Metal–organic frameworks: The future of low-κ materials. NPG Asia Mater. 2016, 8, e333. [Google Scholar] [CrossRef]
 - Velioglu, S.; Keskin, S. Revealing the effect of structure curations on the simulated CO2 separation performances of MOFs. Mater. Adv. 2020, 1, 341–353. [Google Scholar] [CrossRef]
 - Wang, H.-S. Metal–organic frameworks for biosensing and bioimaging applications. Coord. Chem. Rev. 2017, 349, 139–155. [Google Scholar] [CrossRef]
 - Wang, Z.; Huang, J.; Mao, J.; Guo, Q.; Chen, Z.; Lai, Y. Metal–organic frameworks and their derivatives with graphene composites: Preparation and applications in electrocatalysis and photocatalysis. J. Mater. Chem. A 2020, 8, 2934–2961. [Google Scholar] [CrossRef]
 - Zhao, X.; Wang, Y.; Li, D.S.; Bu, X.; Feng, P. Metal-Organic Frameworks for Separation. Adv. Mater. 2018, 30, e1705189. [Google Scholar] [CrossRef]
 - Gholampour, A.; Ozbakkaloglu, T. A review of natural fiber composites: Properties, modification and processing techniques, characterization, applications. J. Mater. Sci. 2019, 55, 829–892. [Google Scholar] [CrossRef]
 - Khan, J.; Siddiq, M.; Akram, B.; Ashraf, M.A. In-situ synthesis of CuO nanoparticles in P(NIPAM-co-AAA) microgel, structural characterization, catalytic and biological applications. Arab. J. Chem. 2018, 11, 897–909. [Google Scholar] [CrossRef]
 - Belmabkhout, Y.; Bhatt, P.M.; Adil, K.; Pillai, R.S.; Cadiau, A.; Shkurenko, A.; Maurin, G.; Liu, G.; Koros, W.J.; Eddaoudi, M. Natural gas upgrading using a fluorinated MOF with tuned H2S and CO2 adsorption selectivity. Nat. Energy 2018, 3, 1059–1066. [Google Scholar] [CrossRef]
 - He, T.; Pachfule, P.; Wu, H.; Xu, Q.; Chen, P. Hydrogen carriers. Nat. Rev. Mater. 2016, 1, 16059. [Google Scholar] [CrossRef]
 - Hafeez, M.; Arshad, R.; Khan, J.; Akram, B.; Ahmad, M.N.; Hameed, M.U.; Haq, S. Populus ciliata mediated synthesis of copper oxide nanoparticles for potential biological applications. Mater. Res. Express 2019, 6, 055043. [Google Scholar] [CrossRef]
 - Akram, B.; Ahmad, K.; Khan, J.; Khan, B.A.; Akhtar, J. Low-temperature solution-phase route to sub-10 nm titanium oxide nanocrystals having super-enhanced photoreactivity. New J. Chem. 2018, 42, 10947–10952. [Google Scholar] [CrossRef]
 - Ahmed, S.; Jiang, X.; Wang, C.; Kalsoom, U.E.; Wang, B.; Khan, J.; Muhammad, Y.; Duan, Y.; Zhu, H.; Ren, X.; et al. An Insightful Picture of Nonlinear Photonics in 2D Materials and their Applications: Recent Advances and Future Prospects. Adv. Opt. Mater. 2021, 9, 2001671. [Google Scholar] [CrossRef]
 - Meilikhov, M.; Yusenko, K.; Esken, D.; Turner, S.; Van Tendeloo, G.; Fischer, R.A. Metals@MOFs—Loading MOFs with Metal Nanoparticles for Hybrid Functions. Eur. J. Inorg. Chem. 2010, 2010, 3701–3714. [Google Scholar] [CrossRef]
 - Huang, H.; Yao, J.; Chen, H.; Zeng, X.; Chen, C.; She, X.; Li, L. Facile preparation of halloysite/polyaniline nanocomposites via in situ polymerization and layer-by-layer assembly with good supercapacitor performance. J. Mater. Sci. 2016, 51, 4047–4054. [Google Scholar] [CrossRef]
 - Song, B.; Wu, Z.; Zhu, Y.; Moon, K.S.; Wong, C.P. Three-Dimensional Graphene-Based Composite for Flexible Electronic Applications. In Proceedings of the Electronic Components & Technology Conference, San Diego, CA, USA, 26–29 May 2015. [Google Scholar]
 - Seifipour, R.; Nozari, M.; Pishkar, L. Green Synthesis of Silver Nanoparticles using Tragopogon Collinus Leaf Extract and Study of Their Antibacterial Effects. J. Inorg. Organomet. Polym. Mater. 2020, 30, 2926–2936. [Google Scholar] [CrossRef]
 - Shekhah, O.; Belmabkhout, Y.; Chen, Z.; Guillerm, V.; Cairns, A.; Adil, K.; Eddaoudi, M. Made-to-order metal-organic frameworks for trace carbon dioxide removal and air capture. Nat. Commun. 2014, 5, 4228. [Google Scholar] [CrossRef]

| Zone of Inhibition (ZOI) Measure in Millimeters (mm) | ||||||
| Standard | Solvent Activity | A1 | A2 | A3 | A4 | |
| Bacteria for Non-calcined Ag NPs | ||||||
| Escherichia coli | 29 | 00 | 10 | 15 | 16 | 20 | 
| S. aures | 29 | 00 | 14 | 15 | 18 | 21 | 
| Bacteria for Calcined Ag NPs | ||||||
| Escherichia coli | 22 | 00 | 15 | 17 | 20 | 22 | 
| S. aures | 22 | 00 | 8 | 10 | 12 | 13 | 
| Sample | Concentration mg/mL | Ao | Ai | %RSA | IC50 | 
|---|---|---|---|---|---|
| Non-calcined Ag NPS | 1 | 0.1 | 0.083 | 17 | 3.28 | 
| 3 | 0.1 | 0.043 | 57 | ||
| 5 | 0.1 | 0.027 | 73 | ||
| 7 | 0.1 | 0.016 | 84 | ||
| Calcined Ag NPS | 1 | 0.1 | 0.085 | 15 | 3.48 | 
| 3 | 0.1 | 0.044 | 56 | ||
| 5 | 0.1 | 0.03 | 70 | ||
| 7 | 0.1 | 0.019 | 81 | 
Disclaimer/Publisher’s Note: The statements, opinions and data contained in all publications are solely those of the individual author(s) and contributor(s) and not of MDPI and/or the editor(s). MDPI and/or the editor(s) disclaim responsibility for any injury to people or property resulting from any ideas, methods, instructions or products referred to in the content.  | 
© 2022 by the authors. Licensee MDPI, Basel, Switzerland. This article is an open access article distributed under the terms and conditions of the Creative Commons Attribution (CC BY) license (https://creativecommons.org/licenses/by/4.0/).
Share and Cite
Khan, J.; Naseem, I.; Bibi, S.; Ahmad, S.; Altaf, F.; Hafeez, M.; Almoneef, M.M.; Ahmad, K. Green Synthesis of Silver Nanoparticles (Ag-NPs) Using Debregeasia Salicifolia for Biological Applications. Materials 2023, 16, 129. https://doi.org/10.3390/ma16010129
Khan J, Naseem I, Bibi S, Ahmad S, Altaf F, Hafeez M, Almoneef MM, Ahmad K. Green Synthesis of Silver Nanoparticles (Ag-NPs) Using Debregeasia Salicifolia for Biological Applications. Materials. 2023; 16(1):129. https://doi.org/10.3390/ma16010129
Chicago/Turabian StyleKhan, Jahanzeb, Irsa Naseem, Saiqa Bibi, Shakeel Ahmad, Faizah Altaf, Muhammad Hafeez, Maha M. Almoneef, and Khalil Ahmad. 2023. "Green Synthesis of Silver Nanoparticles (Ag-NPs) Using Debregeasia Salicifolia for Biological Applications" Materials 16, no. 1: 129. https://doi.org/10.3390/ma16010129
APA StyleKhan, J., Naseem, I., Bibi, S., Ahmad, S., Altaf, F., Hafeez, M., Almoneef, M. M., & Ahmad, K. (2023). Green Synthesis of Silver Nanoparticles (Ag-NPs) Using Debregeasia Salicifolia for Biological Applications. Materials, 16(1), 129. https://doi.org/10.3390/ma16010129
        
